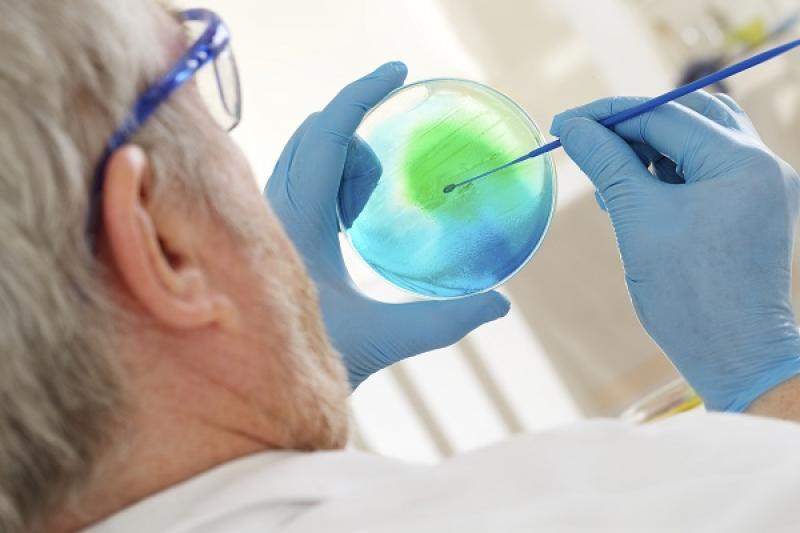

Sponsored
Global Pyrogen Testing Market Size, Share, Trends, and Growth Analysis 2025-2032
The pyrogen testing industry is witnessing robust transformation driven by stringent regulatory protocols and rising demand for safety testing in pharmaceutical and biotechnology sectors. This dynamic market landscape reflects significant growth opportunities influenced by advanced testing technologies and evolving compliance standards.
Market Size and Overview
The global pyrogen testing market size is estimated to be valued at US$ 979.7 million in 2025 and is expected to reach US$ 2,220.5 million by 2032, exhibiting a compound annual growth rate (CAGR) of 12% from 2025 to 2032.
Pyrogen Testing Market Outlook indicates accelerated industry share expansion fueled by technological innovation and increased adoption of in vitro and in vivo test methods. Market trends highlight a preference shift towards alternative testing methods due to rising ethical concerns and regulatory encouragements, providing a substantial market scope for developers and service providers. This comprehensive market report captures evolving pyrogen testing market revenue streams and growth drivers shaping business growth globally.
Get More Insights On- Pyrogen Testing Market